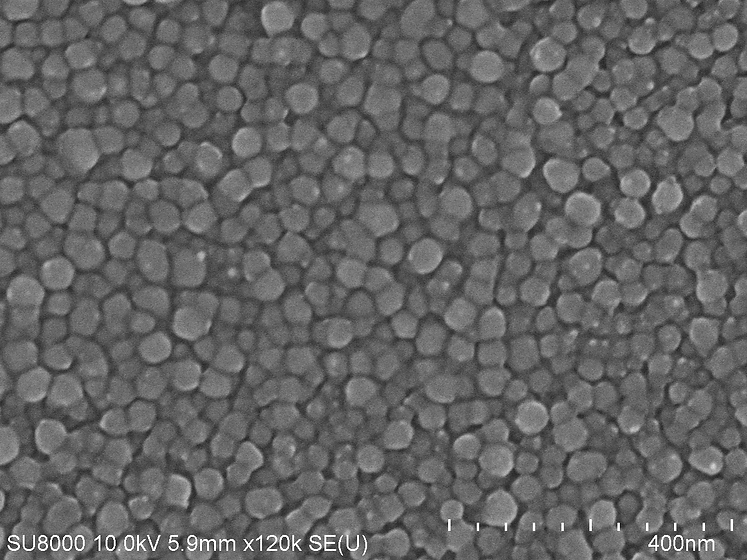

SOLID STATE PHYSICS
Understanding Materials with Physics
ABOUT THE COURSE
This course is designed for undergraduate students who have been studying in materials science, materials physics, and materials related engineering fields. You are going to learn start from basic physic and chemistry and then lead to quantum mechanics, crystallography, and electromagnetism. The very first chapters of this course from 1 to 8 explain about basic principles, laws and theories related with materials. Chapter 8 deals with thermal properties of materials, and next chapter 9 and 10 open the another basic principle, laws and theories for understanding electronic, magnetic and optical properties of materials and then all these properties are studied in last chapters.
ABOUT LECTURER
I'm Chan Thar Soe, research student in Materials Science. Currently I am conducting my research in two dimensional nanomaterials and fabrication of electronic devices.
In 2015, I graduated in Materials Science and Metallurgy from University of Technology (Yatanarpon Cyber City), Pyin Oo Lwin, Myanmar. After that I had worked in Business for one year and studied Business Administration and Management at Strategy First University. In 2016, I moved my carrier to copper production industry as a ISO Officer. In 2017, I resigned my job and applied for scholarship in Mahidol University, Thailand. Currently I have been studying for postgraduate at Materials Science and Nanoengineering program at Mahidol Universtiy, Thailand.






